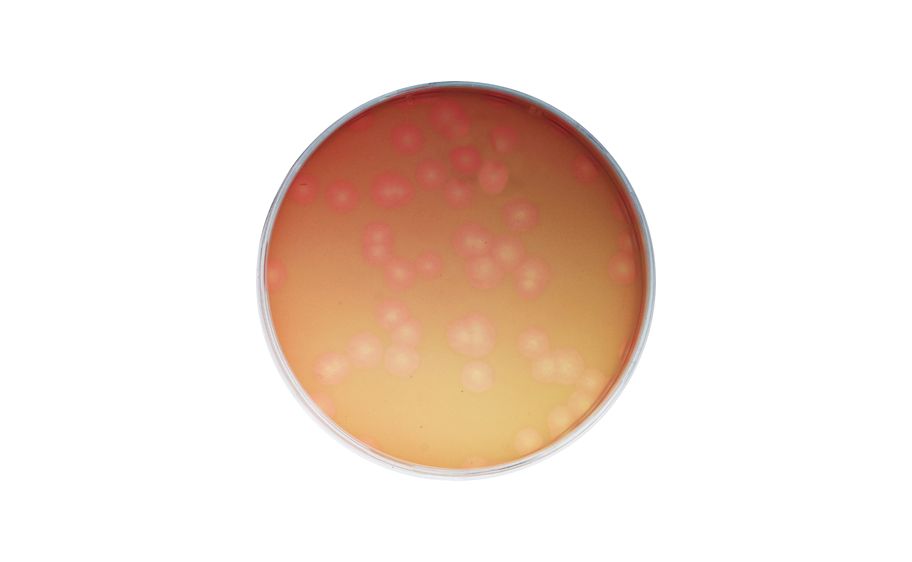
main product photo

Need Help?
800-229-7252

EXPLORING THE BACTERIOPHAGE LIFE CYCLE
1
/
KT
Lead Time
12 Day(s)
SKU
VWR470136-510-KT
MFRPN
209
EXPLORING THE BACTERIOPHAGE LIFE CYCLE
Exploring the Bacteriophage Life Cycle Kit Kit, Exploring the Bacteriophage Life Cycle, Includes: instructions, cells, phage beads, Ready-Pour Agar, COLORTOP* Agar, microtest tubes, sterile loops, petri plates, luria broth.
| Manufacturer | Edvotek |
|---|---|
| MFRPN | 209 |
| Lead Time | 12 Day(s) |
| UNSPSC Code | 41120000 |
Write Your Own Review